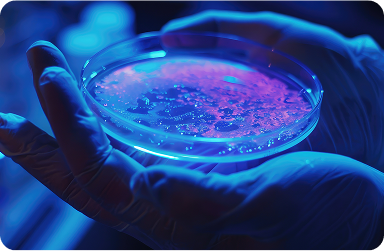
Biotecnologia

BIOECONOMIA

O Habitat Bioeconomia é um ambiente voltado à inovação para empresas que buscam desenvolver
soluções sustentáveis no setor da bioeconomia. Ele integra o ecossistema do Parque Tecnológico
da Indústria e tem como propósito promover ciência, tecnologia, inovação e empreendedorismo,
impulsionando o desenvolvimento competitivo e sustentável.
O Habitat conecta empresas, startups e demais atores do ecossistema em torno de temas como economia circular, biocombustíveis,
bioeconomia florestal, biopolímeros plásticos e biotecnologia. Além disso, oferece espaços de
pesquisa, validação, formação de talentos e desenvolvimento de empreendedores.
Fazer
Desenvolvimento de novos produtos e processos na área de bioeconomia.
Comprar
Validação de tecnologias em escala de laboratório e escala piloto.
Atrair
Formação de talentos para empresas que buscam profissionais para impulsionar inovações e desenvolvimento de empreendedores.
Áreas de atuação

Economia Circular
Transformação de resíduos lignocelulósicos em novos produtos, como:
- Compósitos poliméricos
- Painéis de partículas aglomeradas
- Celulose e papel
- Pellets e briquetes

Biocombustíveis
Produção de combustíveis renováveis a partir de biomassa, incluindo:
- Etanol de 1ª e 2ª geração
- Biogás
- Pellets, briquetes e bio-óleo
- Caracterização de combustíveis e biocombustíveis
- Desenvolvimento de novas fontes de matéria-prima

Bioeconomia Florestal
Uso sustentável de recursos florestais com foco em:
- Controle biológico de pragas
- Produção de celulose, papel e painéis MDP/laminados
- Desenvolvimento de nanocelulose e extratos vegetais
- Tratamento enzimático de fibras

Biopolímeros Plásticos
Pesquisa e desenvolvimento de plásticos a partir de fontes renováveis, com:
- Aplicação de fibras, nanofibras e finos em matrizes poliméricas
- Desenvolvimento de embalagens sustentáveis
Biotecnologia
Aplicação de processos biológicos para novos produtos, como:
- Extratos de folhas com propriedades funcionais para alimentos
- Formulação de bebidas proteicas ricas em colágeno
Receba novidades direto no seu e-mail!